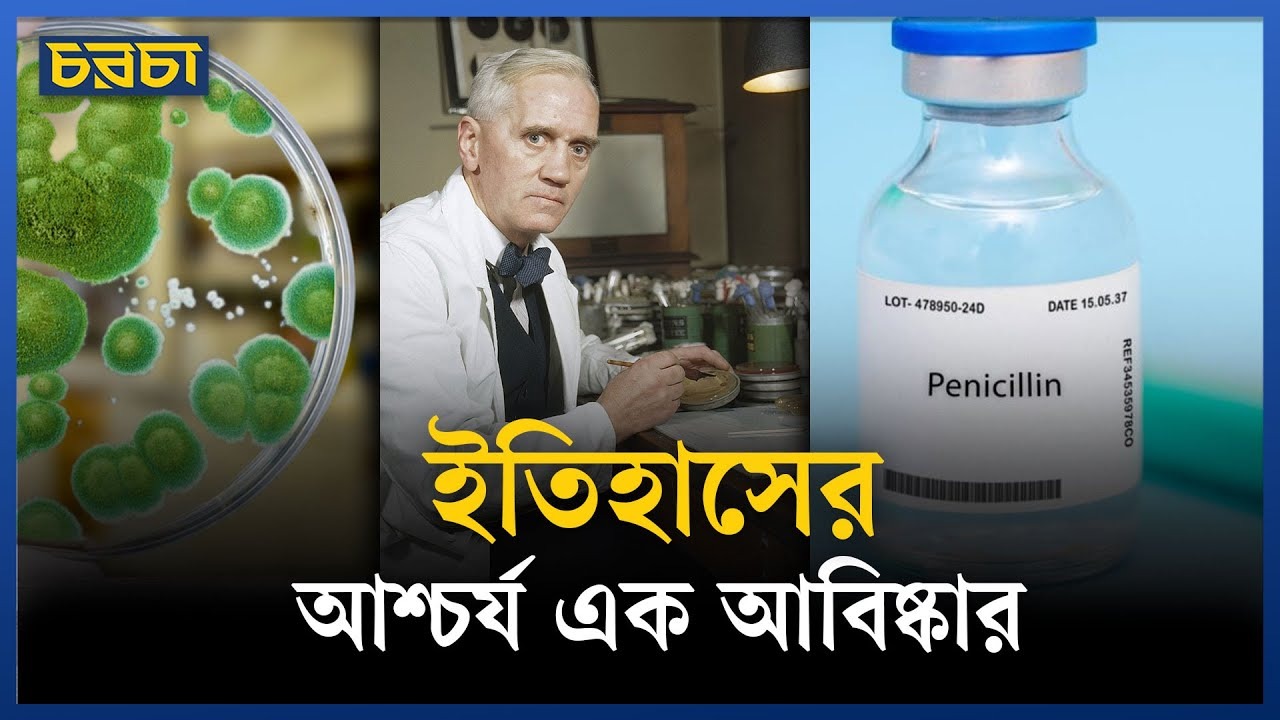
শত বছর আগের এই ওষুধ এখনো জীবন বাঁচায়

প্রতিটি জীব জন্ম নেয় বেঁচে থাকার তাগিদে। প্রাণিজগতে এমন কিছু প্রজাতি আছে যাদের কাছে যৌনক্রিয়া মানেই মৃত্যু। কেন এই আত্মঘাতী প্রেম? কেন বংশবিস্তারের নেশা জীবনের চেয়েও বড় হয়ে ওঠে?

বিশেষ কোভিড মহামারির সময় থেকে মানুষ ইন্সট্যান্ট নুডলস দিয়ে নানা ধরনের নিরীক্ষাধর্মী রেসিপি ফুড ট্রেন্ডের শীর্ষে চলে আসে। তবে এই খাবারটি আমাদের ক্ষুধা মেটালেও এটি শরীরের জন্য কতটা উপকারী বা অপকারী, তা নিয়ে দীর্ঘকাল ধরে বিতর্ক চলছে।

হোয়াটসঅ্যাপ, মেসেঞ্জারের যুগে ল্যান্ডলাইনের দিনগুলোর কথা মনে পড়ে? কেমন ছিল সেই যোগাযোগ? ক্রস কানেকশনের বিড়ম্বনা, কিংবা ট্রাঙ্ককলে চিৎকার করে কথা বলা। অচেনা নম্বরে ফোন ঘুরিয়ে সুন্দর কণ্ঠের কারও সঙ্গে কথা বলা। বাড়ির ল্যানলাইনে কারও ফোন এলে সবার মনোযোগ এড়িয়ে কথা বলার চেষ্টা…

১১:১১ কেবল একটি সময় নয়, অনেকের কাছে এটি এক ধরনের ঘটনা। বিশ্বাস করা হয়, এই সংখ্যা বারবার দেখা মানে মহাবিশ্বের কোনো বার্তা বা আধ্যাত্মিক সামঞ্জস্যের ইঙ্গিত।

দুপুর ২-৩টার ঝিমুনি অলসতা নয়, এটা শরীরের স্বাভাবিক সংকেত। মাত্র ১০ থেকে ২০ মিনিটের এই বিশ্রাম আপনার মস্তিষ্ককে এমনভাবে বুস্ট করে যা অন্য কিছুতে সম্ভব নয়। এজন্যই তো একে বলে ‘পাওয়ার ন্যাপ’। তবে বাঙালিদের ভাতঘুমের সঙ্গে একে গুলিয়ে ফেললেই বিপদ!

তাদের অফরোড ড্রাইভিংয়ের শখ। মূলত জিপের এসইউভি গাড়ি চালাতেন তারা মনের আনন্দে। গাড়ি চালানোর রোমাঞ্চটা উপভোগ করতে করতেই ‘জিপারস অ্যানোনিমাস’ গড়ে তোলা। সেই উদ্যোগই এখন তুষার ঝড়ের মধ্যে বরফাচ্ছন্ন রাস্তায় কাজ করছে মানুষের জীবন রক্ষায়।

ভারতীয় সংবাদমাধ্যম দ্য ইন্ডিয়ান এক্সপ্রেসকে মহারাষ্ট্রের থানেতে অবস্থিত জুপিটার হাসপাতালের পরিচালক (ইন্টারনাল মেডিসিন) ডা. অমিত সারাফ জানান, স্বাস্থ্যকর খাবার খাওয়ার পরেও অনেকের ওজন না কমার পেছনে বড় কারণ হতে পারে অনিয়মিত ঘুমের অভ্যাস।

অনেক বাথরুমেই অপ্রয়োজনীয় অনেক জায়গা রাখা হয়। এগুলো আবার বিল্ট-ইন ক্যাবিনেট থেকে শুরু করে খালি দেয়াল, যা শেলফ বসানোর জন্য একদম উপযুক্ত। তবে তাই বলে বাথরুমে সবকিছু রাখা কিন্তু নিরাপদ নয়।

ঘুমের আগে মাত্র পাঁচ মিনিট ধ্যান করলেও তা বিস্ময়করভাবে কার্যকর হতে পারে। এটি মস্তিষ্ককে সক্রিয় ও সতর্ক অবস্থা থেকে শান্ত ‘প্যারাসিমপ্যাথেটিক’ অবস্থায় নিয়ে আসে।

যানজট ঢাকার একটি দীর্ঘস্থায়ী ও জটিল সমস্যা। এর কারণে দৈনিক লাখ লাখ কর্মঘণ্টা নষ্ট হচ্ছে। শুধু তাই নয়, যানজট হচ্ছে মানুষের মৃত্যুর কারণও। যানজটে আটকে থাকে রোগী ও আহত ব্যক্তিবাহী অ্যাম্বুলেন্স। ফলে অনেকে সড়কেই শেষ নিশ্বাস ত্যাগ করেন।

সারাদিন মুখে থাকা মেকআপ, ধুলাবালি ও ময়লা যদি রাতে পরিষ্কার না করা হয়, তাহলে ত্বকের ছোট ছোট পোরস বা রোমকূপ বন্ধ হয়ে যেতে পারে। এতে ব্রণ বা পিম্পলের মতো সমস্যা দেখা দিতে পারে।

কেমন ছিল ঢাকা? কার ঘুড়ি কত উঁচুতে উঠত? ঢাকার ফেলে আসা জীবনে ঘুড়ি ওড়ানোর চলটা কেমন ছিল? ঘুড়ি নিয়ে ঢাকার মহল্লার সংস্কৃতি কেমন ছিল? সাকরাইনকে ঘিরে ঘুড়ির সেই জগৎই যেন হাতছানি দিয়ে ডাকছে। ঘুড়ি নিয়ে নানা স্মৃতি নিয়েই এবারের ফেরারি মন…
পেনিসিলিন এক বিস্ময়কর আবিষ্কার। আজ থেকে প্রায় শত বছর আগের এই আবিষ্কার এখনো জীবন বাঁচাতে রাখছে ভূমিকা। কীভাবে আবিষ্কার হয়েছিল পেনিসিলিন? এ নিয়েই চরচার আজকের টিকটেক

শরীর থেকে টক্সিন বের করে দেওয়া এর প্রধান কাজ। যখন লিভার সঠিক উপায়ে কাজ করতে পারে না, তখন রক্তে টক্সিনের মাত্রা বেড়ে যায়।

শরীর থেকে টক্সিন বের করে দেওয়া এর প্রধান কাজ। যখন লিভার সঠিক উপায়ে কাজ করতে পারে না, তখন রক্তে টক্সিনের মাত্রা বেড়ে যায়।